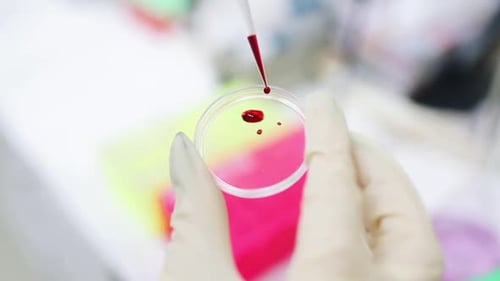
Adding Blood Sample to Petri Dish in Lab

Royalty-Free 720p (HD) Animal Testing Stock Footage
Browse 720p (HD) animal testing stock videos in our library. If you can't find what you're looking for at first glance, try using the filters!
How satisfied are you with your Stock Video experience today?